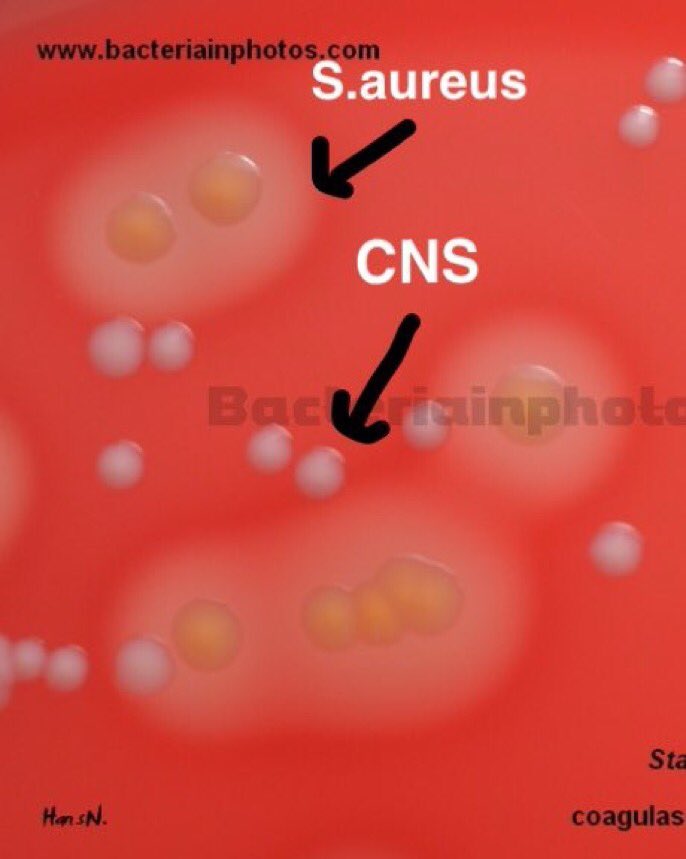
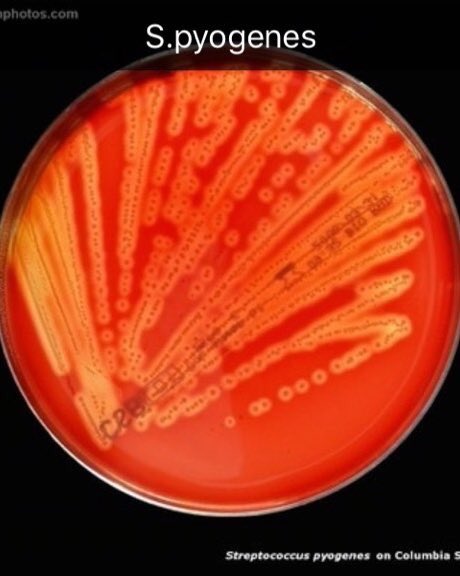
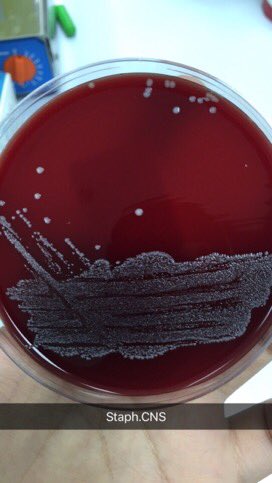
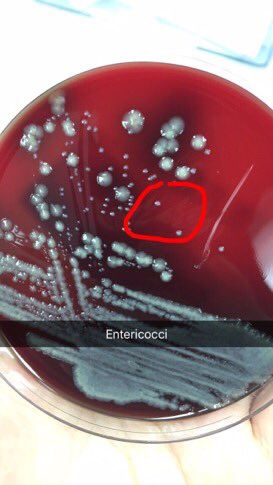
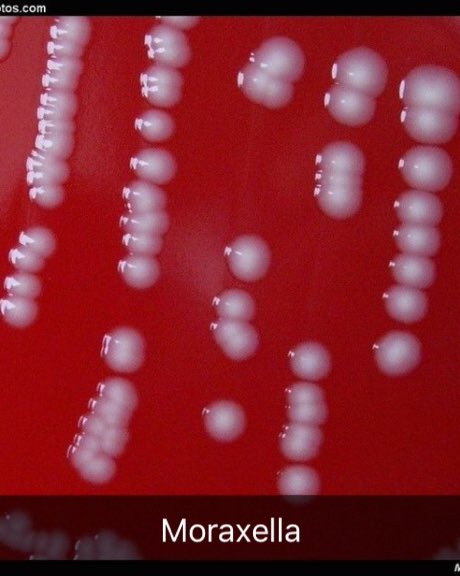
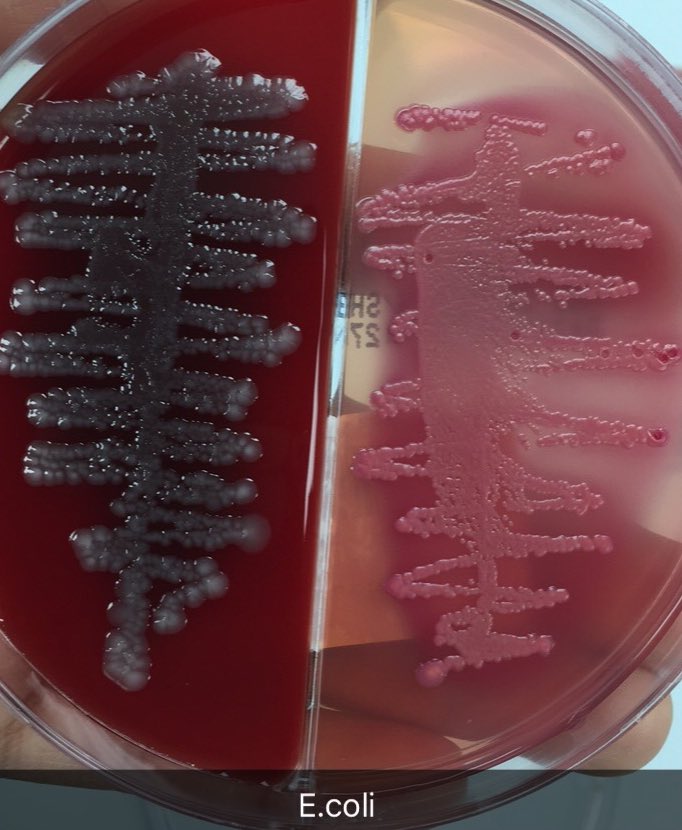
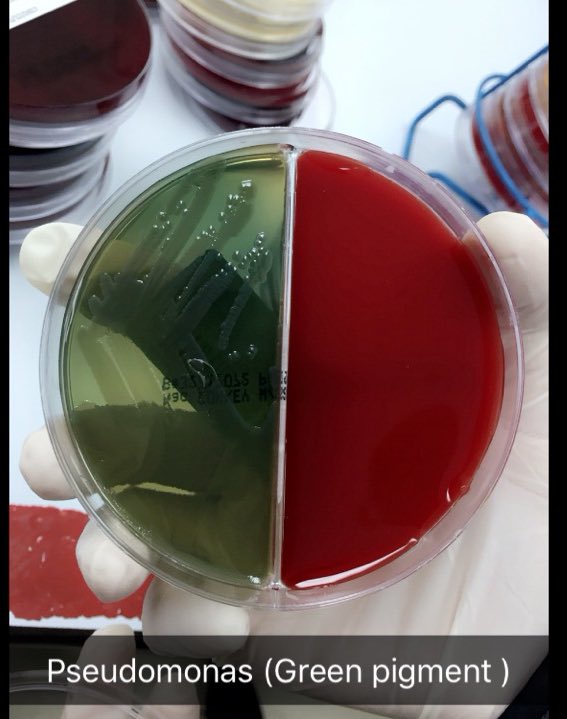
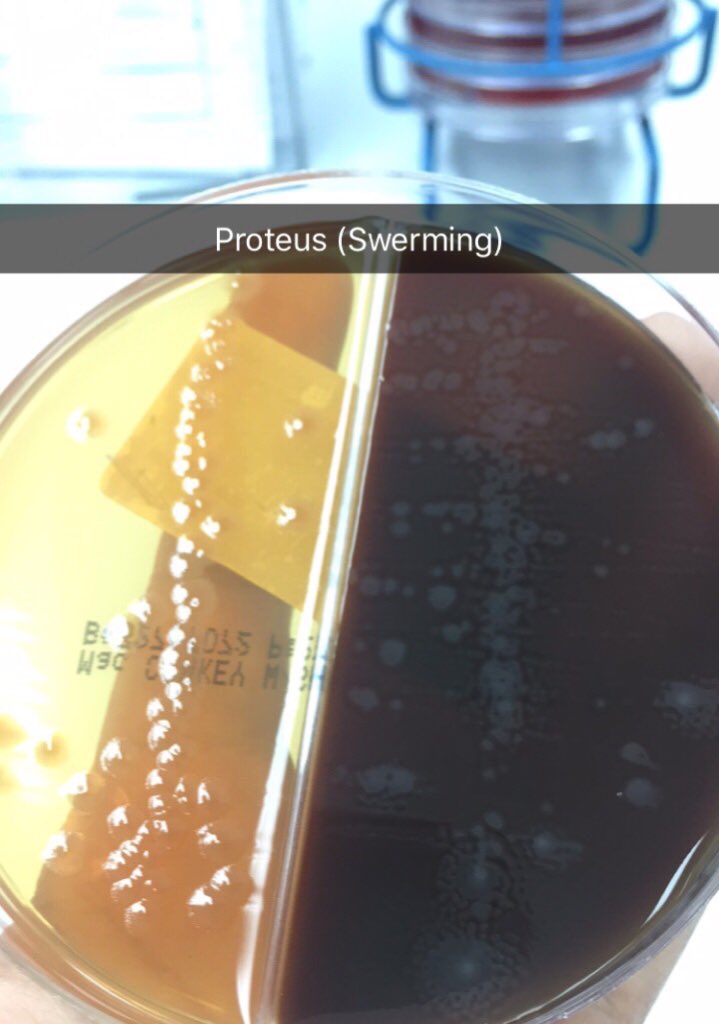
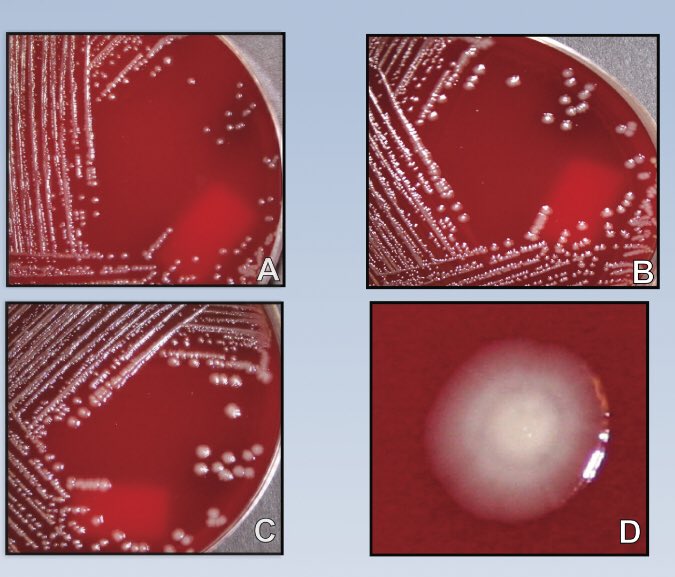
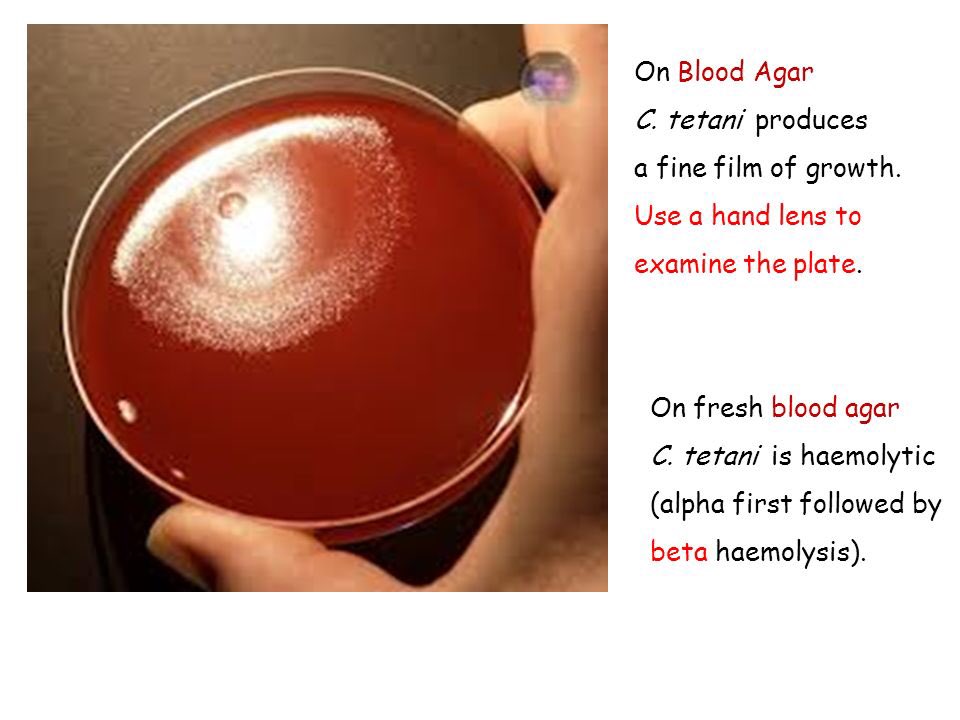
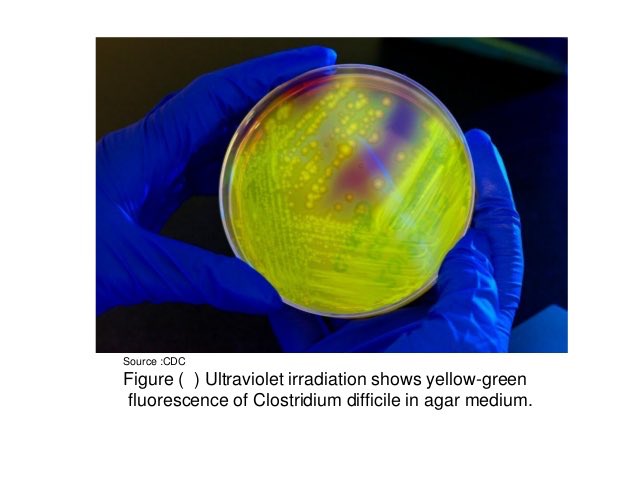
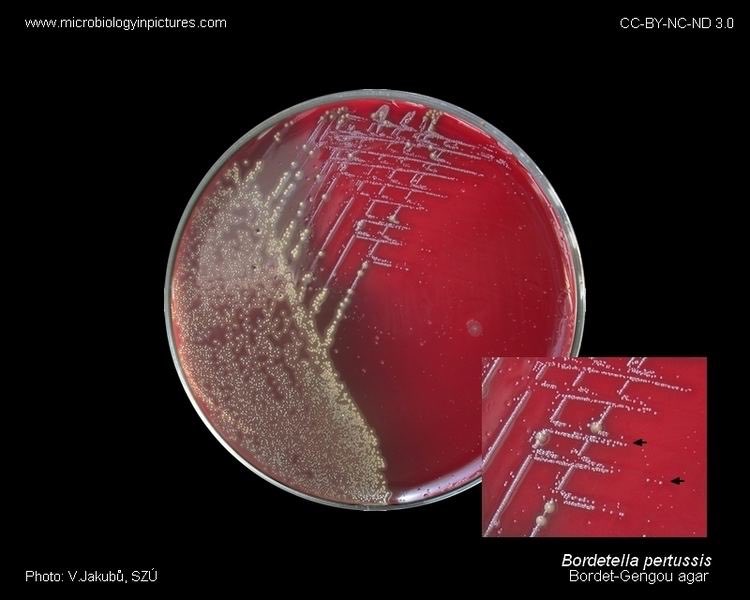
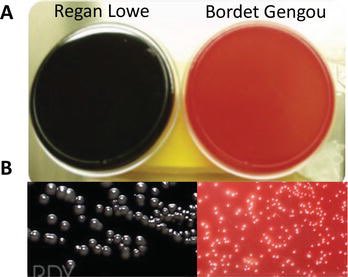
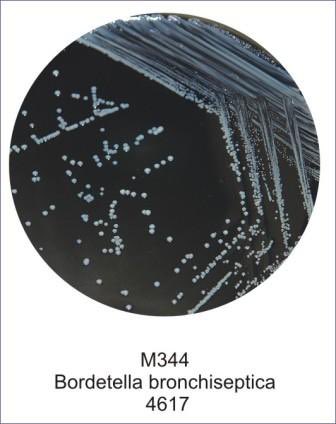

تابع ملخص المايكرو 👩🏻🔬🌸
Media
1/blood agar 🔴: GP,GN,Yeast
*Type of hemolysis (Alpha,Beta,Gama)
2/chocolate agar🍩:GP,GN,yeast
اهم بكتيريا في هذا النوع هي Haemophilus Influenzae
لانها تنمو فيه فقط 👌🏼
3/Macconcy agar 🌺: just GN
وذلك لوجود crystal violet and bile salt
Media
1/blood agar 🔴: GP,GN,Yeast
*Type of hemolysis (Alpha,Beta,Gama)
2/chocolate agar🍩:GP,GN,yeast
اهم بكتيريا في هذا النوع هي Haemophilus Influenzae
لانها تنمو فيه فقط 👌🏼
3/Macconcy agar 🌺: just GN
وذلك لوجود crystal violet and bile salt
تابع macconcy agar 🌺 (Lactose ferment,non lactose ferment )
4/XLD agar 🌸: for Stool
(Salmonella 🌑black colony )(Shigella colorless)
(Normal flora 🌕 yellow colony)
5/Bile esculin agar 🎾: just Enterococcus -dark brown ,black colony🌑
6/Mannitol salt agar :MRSA screening
4/XLD agar 🌸: for Stool
(Salmonella 🌑black colony )(Shigella colorless)
(Normal flora 🌕 yellow colony)
5/Bile esculin agar 🎾: just Enterococcus -dark brown ,black colony🌑
6/Mannitol salt agar :MRSA screening
راح اتكلم عن عن عدة انواع من البكتيريا وراح اختار الحالات المتكررة في المختبر وكيف معرفة شكلها تحت المايكروسكوب 🔬و كيف يكون شكلها عند عمل مزرعة لها 🔴(culture ) 👩🏻🔬🌸
Gram(+)🔵
Bacilli anaerobic 🚫
Clostridium types:
C. botulinum
C. perfringens
C. tetani
راح اتكلم عن كل وحدة لحالها لانها مهمة
Bacilli anaerobic 🚫
Clostridium types:
C. botulinum
C. perfringens
C. tetani
راح اتكلم عن كل وحدة لحالها لانها مهمة
المعلومة المهمة عن المرضTetanus هي ان الاصابة به عن طريق الاصابة بمسمار ملوث بالكبتيريا المسببه له وهي (C.tetani) الي سبق ذكرها لذلك عند التعرض بجرح بواسطة مسمار او اي معدن يجب الذهاب الى المستشفى من اجل اخذ ابرة التسمم👌🏼مع المحافظة على التطعيمات الموصى بها شاهد الفيديو 👩🏻🔬
هذا فيديو مرض الTetanus👩🏻🔬🔬
youtu.be
youtu.be
اليوم راح نكمل بعض انواع البكتيريا المهمة الممتعة 😍👌🏼🧫 ننطلق 🌚
@xa11sn حاضر🙏🏻✨
جاري تحميل الاقتراحات...